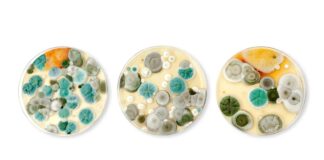
Визначення поширених видів цвілі в приміщенні: посібник із ризиків для здоров’я та профілактики

додому Блог
Популярні
Обвязка фундаменту на гвинтових палях
maxwelhelp - 0
Обвязка фундаменту на гвинтових палях Пальово-гвинтові фундаменти користуються досить великою популярністю в приватних забудовників. Особливо затребувані вони бувають при зведенні щодо легких каркасних будинків чи будівель з бруса.
Рекомендуемо
Converse — чому бренд створює настільки популярне взуття, одяг та аксесуари
maxwelhelp - 0
Converse — чому бренд створює настільки популярне взуття, одяг та аксесуари
Converse — один із небагатьох брендів, який зміг пройти шлях від спортивного виробника до...
Как выбрать масло для террасы и уличных покрытий
maxwelhelp - 0
Дерево, находящееся на улице, ежедневно подвергается воздействию влаги, ультрафиолета, перепадов температур и механических нагрузок. Без правильной обработки оно быстро теряет внешний вид, трескается, темнеет...
Противопожарные решения от КЗПО: двери, ворота и люки для комплексной безопасности
maxwelhelp - 0
КЗПО (Киевский завод пожарного оборудования) — это специализированный украинский производитель, который сосредоточен на создании надежных противопожарных конструкций. Подробную информацию о продукции можно найти на...
Як вибрати домофон
maxwelhelp - 0
Конструктивні особливості моделей і їх відмінності
Класифікація відеодомофонів для будинку або офісу заснована на їх функціональні можливості, а також як екран, які безпосередньо впливають на...